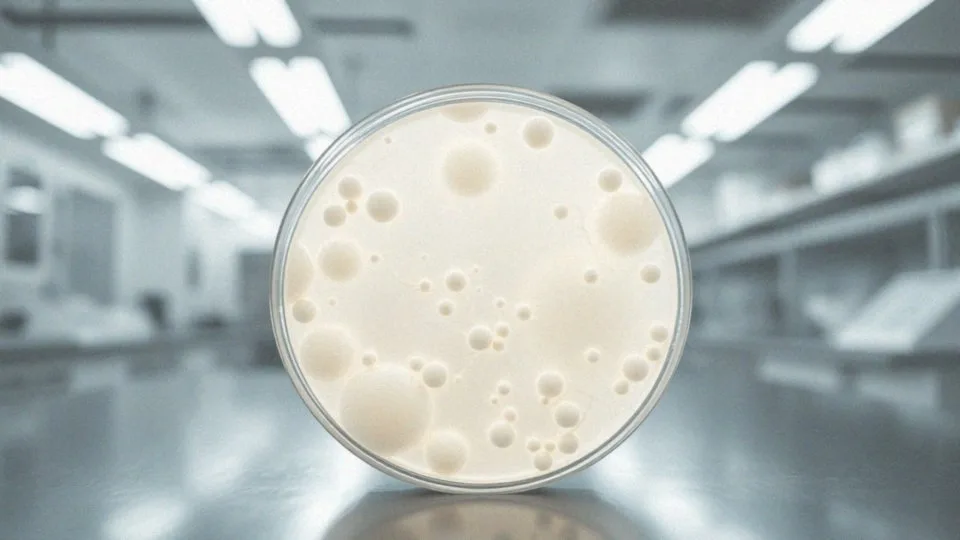
Jak działa Oktaseptal na bakterie?

Spis treści
Co to jest Oktaseptal do jamy ustnej?
Oktaseptal to środek do płukania jamy ustnej, który ma za zadanie zapewnić skuteczną ochronę przed infekcjami. Stosuje się go głównie do odkażania, co jest szczególnie ważne w przypadku:
- aft,
- różnorodnych podrażnień,
- zabiegów stomatologicznych.
Dzięki aktywnym składnikom, które wykazują działanie bakteriobójcze, wirusobójcze i grzybobójcze, preparat działa na wielu frontach. Regularne stosowanie Oktaseptalu znacząco zmniejsza ryzyko wystąpienia infekcji w jamie ustnej, a także wspomaga gojenie się ran i podrażnień. Jego łatwość w użyciu sprawia, że stanowi wygodne rozwiązanie dla osób pragnących dbać o zdrowie swojej jamy ustnej.
Jakie są aktywne substancje w Oktaseptal?
Aktywnymi składnikami preparatu Oktaseptal są:
- oktenidyny dichlorowodorek – wykazuje działanie bakteriobójcze, wirusobójcze oraz grzybobójcze, co czyni go skutecznym środkiem dezynfekującym,
- fenoksyetanol – wzmacnia efekty antyseptyczne oktenidyny, tworząc efektywne połączenie.
To pozwala na skuteczne odkażanie jamy ustnej, istotne w leczeniu stanów zapalnych oraz zapobieganiu infekcjom. Zaleca się stosowanie preparatu przed i po zabiegach stomatologicznych, a także w sytuacji podrażnienia błony śluzowej. Dzięki tym właściwościom, Oktaseptal przyczynia się do lepszego zdrowia jamy ustnej.
Jak działa Oktaseptal na bakterie?
Oktaseptal skutecznie zwalcza bakterie dzięki obecności oktenidyny dichlorowodorku, kluczowego składnika preparatu. Jego działanie polega na naruszaniu błon komórkowych mikroorganizmów, co prowadzi do ich śmierci. Preparat dobrze radzi sobie zarówno z bakteriami Gram-dodatnimi, jak i Gram-ujemnymi, co czyni go efektywnym środkiem dezynfekującym w jamie ustnej.
Badania laboratoryjne wykazały, że oktenidyna jest w stanie zwalczać różnorodne szczepy bakterii, w tym te, które powodują poważne stany zapalne oraz inne problemy w obrębie jamy ustnej. Systematyczne stosowanie Oktaseptalu korzystnie wpływa na zdrowie błony śluzowej, obniża ryzyko infekcji i przyspiesza proces gojenia. Dzięki swoim bakteriobójczym właściwościom, preparat staje się nieodłącznym elementem codziennej pielęgnacji jamy ustnej.
Jest to szczególnie istotne dla osób mających problemy zdrowotne w tej okolicy lub po zabiegach stomatologicznych, gdzie ryzyko infekcji jest znacząco zwiększone.
W jakich przypadkach należy stosować Oktaseptal?
Oktaseptal to preparat o szerokim zastosowaniu, który przede wszystkim znajduje swoje miejsce w dezynfekcji jamy ustnej. Można go stosować w przypadku:
- uporczywych aft,
- podrażnień błony śluzowej,
- stanów zapalnych w jamie ustnej.
Działa skutecznie na gojenie drobnych ran i owrzodzeń, co czyni go doskonałym wyborem przy urazach mechanicznych czy zadrapaniach. Rekomenduje się użycie Oktaseptalu zarówno przed, jak i po zabiegach stomatologicznych, ponieważ zmniejsza ryzyko infekcji i wspomaga regenerację tkanek. Sesja jego stosowania ma również swoje miejsce w pielęgnacji ran oraz szwów pooperacyjnych, co jest niezwykle istotne dla ogólnego zdrowia jamy ustnej. Co więcej, Oktaseptal może przynieść ulgę w problemach z grzybicą jamy ustnej.
Jest on pomocny również podczas noszenia aparatów ortodontycznych oraz protez, ułatwiając utrzymanie odpowiednich standardów higienicznych. Regularne płukanie jamy ustnej tym preparatem przyczynia się do efektywnej dezynfekcji oraz poprawia ogólną kondycję dotkniętych obszarów, co pozwala na uniknięcie wielu powikłań oraz infekcji.
Jakie są przeciwwskazania do stosowania Oktaseptal?
Oktaseptal ma kilka przeciwwskazań, które warto znać. Głównymi z nich są:
- nadwrażliwość na oktenidynę dichlorowodorek,
- fenoksyetanol,
- inne składniki preparatu.
Ważne jest, aby nie stosować go do płukania jamy brzusznej ani w kontakcie z krwiobiegiem. Używanie tego środka na dużych obszarach skóry również może być problematyczne, zwłaszcza u osób z zaburzeniami nerek. Jeśli pojawią się jakiekolwiek objawy alergiczne, konieczne jest natychmiastowe zaprzestanie jego stosowania oraz skonsultowanie się z lekarzem. Zachowanie bezpieczeństwa pacjentów jest niezwykle istotne, aby uniknąć potencjalnych poważnych skutków ubocznych.
Jakie są działania niepożądane związane z używaniem Oktaseptal?

Oktaseptal może wywoływać pewne skutki uboczne. Wśród najczęstszych należą:
- łagodne podrażnienia błony śluzowej,
- uczucie pieczenia,
- zaczerwienienie w miejscu aplikacji.
Rzadziej zdarzają się reakcje alergiczne, objawiające się:
- swędzeniem,
- wysypką,
- obrzękiem.
Jeśli wystąpią poważniejsze symptomy, takie jak trudności w oddychaniu czy obrzęk twarzy, należy natychmiast przerwać stosowanie preparatu i skontaktować się z lekarzem. Ważne jest, aby bacznie obserwować reakcje organizmu na ten środek, co pozwoli uniknąć ewentualnych komplikacji zdrowotnych. Osoby z alergiami powinny szczególnie uważać na stosowanie Oktaseptalu, aby zminimalizować ryzyko negatywnych reakcji.
Jak płukać jamę ustną za pomocą Oktaseptal?
Aby skutecznie używać preparatu Oktaseptal do płukania jamy ustnej, warto postępować według kilku kluczowych kroków:
- odmierzyć 20 ml nierozcieńczonego roztworu,
- płucz usta przez około 20 sekund z intensywnością,
- po upływie czasu wypluj płyn, dbając o to, by go nie połknąć, co jest istotne dla Twojego bezpieczeństwa.
Zaleca się powtarzać tę procedurę kilka razy w ciągu dnia, zgodnie z radami lekarza lub farmaceuty. Takie rytuały nie tylko dezynfekują jamę ustną, ale także wspomagają proces gojenia w przypadku stanów zapalnych i podrażnień. Dodatkowo, regularne płukanie zwiększa skuteczność Oktaseptalu, co przyczynia się do ogólnej poprawy zdrowia jamy ustnej.
Jak długo utrzymuje się działanie Oktaseptal?
Oktaseptal zaczyna działać już po zaledwie minucie po aplikacji, co czyni go wyjątkowo efektywnym środkiem do dezynfekcji jamy ustnej. Jego działanie utrzymuje się przez około 60 minut, zapewniając długotrwałą ochronę przed szkodliwymi drobnoustrojami. W tym czasie preparat wykazuje silne działanie:
- bakteriobójcze,
- wirusobójcze,
- grzybobójcze,
co jest niezwykle ważne w profilaktyce infekcji oraz wspomaganiu procesu gojenia ran. Oktaseptal okazuje się szczególnie przydatny po zabiegach stomatologicznych oraz w sytuacjach, gdy błona śluzowa ulega podrażnieniom. Regularne stosowanie preparatu może znacznie poprawić stan zdrowia jamy ustnej, minimalizując ryzyko wystąpienia stanów zapalnych oraz innych dolegliwości w tym obszarze.
Jakie są alternatywy dla Oktaseptal w dezynfekcji jamy ustnej?
W poszukiwaniu alternatyw dla Oktaseptal w dziedzinie dezynfekcji jamy ustnej można sięgać po różnorodne skuteczne środki antyseptyczne. Na przykład:
- chlorheksydyna cieszy się dużą popularnością w płynach do płukania ust, ze względu na swoje właściwości bakteriobójcze oraz wirusobójcze,
- preparaty bazujące na wodzie utlenionej, które nie tylko eliminują bakterie, ale również sprzyjają gojeniu ran,
- jodopowidon to inna substancja, której dezynfekujące i antybakteryjne działanie znane jest od lat,
- płyny z olejkami eterycznymi, takimi jak olejek z drzewa herbacianego lub mięty pieprzowej, ponieważ te naturalne składniki wspierają zdrowie jamy ustnej dzięki swoim właściwościom antyseptycznym.
Zanim jednak zdecydujemy się na którykolwiek z tych preparatów, dobrze jest skonsultować się z lekarzem lub farmaceutą. Taki krok pozwoli dopasować odpowiedni środek do indywidualnych potrzeb oraz specyfiki problemów zdrowotnych, co jest kluczowe dla zapewnienia zarówno skuteczności, jak i bezpieczeństwa leczenia antyseptycznego.






